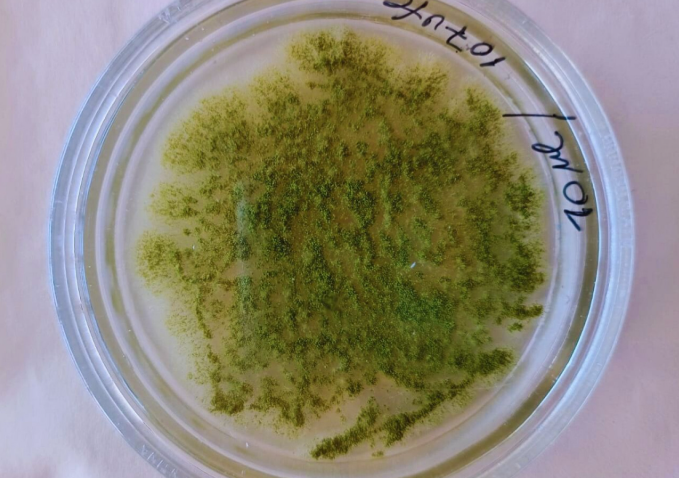

Según datos de la FAO (Organización de Naciones Unidas para la Agricultura y la Alimentación), un 25 % de los cultivos del mundo son afectados por “micotoxinas” provenientes de hongos, lo cual genera enormes pérdidas económicas y un grave riesgo para la salud de animales y personas.
Una de las formas de combatirlos es aplicar productos químicos antifúngicos, lo cual a la larga genera resistencia, y obliga a aplicar dosis mayores, con el consecuente aumento de los costos y de la contaminación ambiental.
En medio de este panorama, investigadores del CONICET, el INTA y la Facultad de Farmacia y Bioquímica de la Universidad de Buenos Aires (FFyB, UBA) trabajan en el desarrollo de un nuevo producto natural para combatir a un grupo de hongos que afectan a cereales y oleaginosas durante su almacenamiento y post cosecha.
El antifúngico en cuestión está siendo formulado a partir de un extracto del árbol Ibirá pitá, (Peltophorum dubium) nativo del bosque chaqueño, que posee la capacidad de controlar el crecimiento de hongos de la especie Aspergillus flavus.
Este hongo, que crece en cereales y oleaginosas con condiciones de humedad, genera un tipo de toxinas que pueden ocasionar lesiones y cáncer hepático tanto en animales como en los seres humanos.

Antifúngico natural
El árbol Ibirá pitá, natural del chaco y la selva misionera, puede alcanzar hasta cuarenta metros de altura y llama la atención por sus flores amarillas. Su interés ornamental ha extendido su presencia al arbolado urbano de Buenos Aires y otras ciudades del país. Sin embargo, “la mayor actividad antifúngica se observó en muestras de las hojas de árboles provenientes de las regiones del noreste del país”, aclaró Lucía Di Ciaccio, investigadora del INTA, e integrante del equipo liderado por Renée Fortunato, directora del Instituto de Botánica Darwinion, perteneciente al CONICET.
“Actualmente estamos desarrollando un prototipo de bioinsumo y lo estamos probando en granos de maíz en el laboratorio. Luego, hay que poder escalarlo para su aplicación en los cereales antes del ingreso al silo”, apunta Di Ciaccio.
Es en esta etapa entre la poscosecha y el almacenamiento cuando ocurre la mayor proliferación de hongos que deterioran los granos, provocando pérdidas económicas y riesgos para la salud humana y animal. Esto se debe a la abundante carga de esporas que acarrean los granos desde el campo, lo que, sumado a condiciones inadecuadas de almacenamiento como la elevada humedad, pueden llevar a la formación de micotoxinas que afectan tanto a animales como a las personas.
Por su parte, Fortunato, del Instituto Darwinion, destaca que “la producción del biofungicida a partir de extractos de un árbol nativo implica el manejo sustentable de este recurso genético silvestre, contemplando el desarrollo económico y el bienestar de las comunidades que viven en la zona”.
Una vez probada su eficacia a campo, la idea es transferir la tecnología de desarrollo del innovador bioproducto al sector agroindustrial para ser utilizado en forma exclusiva o en combinación (sinergismo) con otros productos antifúngicos existentes en el mercado.
Tanto en el mundo como en Argentina, el desarrollo de productos innovadores y sustentables para mejorar el rendimiento de los cultivos es una tendencia en ascenso. Para los productores, la principal ventaja es el ahorro de costos, ya que los bioproductos suelen reemplazar a productos químicos importados. Para los consumidores, el beneficio es contar con alimentos más saludables y nutritivos, que a su vez son amigables con el ambiente.